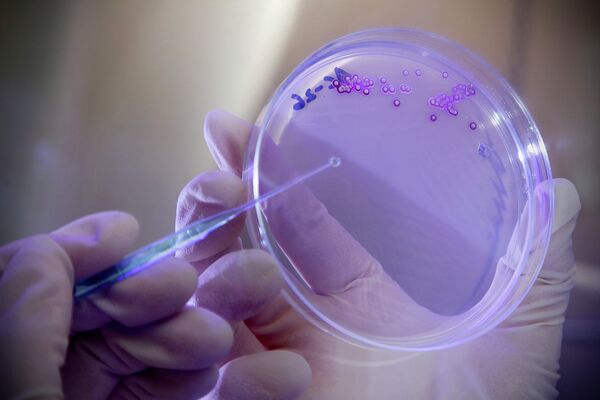
Micróbios militarizados? Pentágono está criando bactérias para detectar explosivos no subsolo - Sputnik Brasil

O objetivo do projeto, iniciado pela Agência de Projetos de Pesquisa Avançada de Defesa (DARPA), é "programar duas cepas bacterianas para monitorar superfícies terrestres de materiais explosivos", disse a Raytheon em um comunicado de imprensa conjunto com o Instituto Politécnico de Worcester (EUA).
Anteriormente, a DARPA já havia liderado programas para criar supersoldados telecinéticos e insetos robóticos armados.
A primeira das duas cepas bacterianas, conhecida como biossensor, "detectará a presença ou ausência de explosivos enterrados no subsolo", enquanto a segunda produzirá uma "luz incandescente" caso esses materiais sejam encontrados.
Arma biológica?
Câmeras ou drones operados remotamente seriam então enviados para inspecionar a área em busca de germes brilhantes e, finalmente, os explosivos enterrados.
"Já sabemos que algumas bactérias podem ser programadas para serem muito boas na detecção de explosivos, mas é mais difícil no subsolo", disse a pesquisadora da Raytheon, Allison Taggart.
Estamos investigando como transportar a bactéria citada até a profundidade necessária no subsolo.
Embora a iniciativa seja supostamente destinada a detectar dispositivos explosivos improvisados enterrados em zonas de guerra estrangeiras, Taggart não escondeu que o "design modular" do sistema de entrega de bactérias e os "componentes" intercambiáveis no interior permitem outras aplicações "conforme necessário".
A sede do Departamento de Defesa dos Estados Unidos afirma que só planeja usar o sistema para fins "defensivos", mas há quem acredite que a ideia de micróbios militarizados seja arriscada, podendo gerar cenários apocalípticos envolvendo uma superbactéria geneticamente modificada.